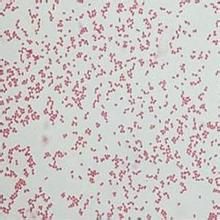
不動桿菌感染 不動桿菌感染

流行病學
在醫院內,病人和工作人員的皮膚是不動桿菌的寄居所,可能是大多數醫院內感染暴發的來源。接觸患者的護士手上攜帶流行株者高達29%,感染的患者皮膚經常帶菌,患者在病房之間移動極易造成醫院內感染。醫院內非生物貯菌所包括醫療器械、室內空調機、機械通氣裝置、氧氣濕化瓶、面罩、氣管插管、血管導管、腹膜透析、保留導管等。病房設備的細菌污染如床罩、浸濕的床褥等均可傳播本菌,此外,亦可通過醫務人員帶菌的手在治療操作中傳播為一重要傳播途徑。還可通過污染的醫療器械傳播由於該菌在環境中存活時間長,乾燥濾紙上可存活6天在乾燥手指上存活36~72h,易形成氣溶膠由空氣傳播。不動桿菌感染的高危因素有惡性腫瘤燒傷、腹膜透析接受皮質激素治療、放療、化療和免疫抑制劑治療行。重症監護病房(ICU)、腎臟科病房、燒傷科病房、新生兒病房等為高危病區。病因
不動桿菌感染發病機制
不動桿菌屬是條件致病菌,也是人體正常菌叢的組成部分。本菌寄居在人的皮膚、結膜、鼻咽、胃腸道、泌尿道、唾液等中,25%正常皮膚攜帶此菌7%成人和嬰兒咽部可短暫帶菌45%的氣管切開處有不動桿菌定植。本菌致病力並不強其中以鮑曼不動桿菌、醋酸鈣不動桿菌和洛菲不動桿菌的致病力較強其致病的毒力因子較少,主要可能與細菌素、莢膜、菌毛等有關該菌在一般情況下不引起疾病,只有在機體抵抗力下降時可引起感染。目前臨床感染的不動桿菌中鮑曼不動桿菌和菌醋酸鈣不動桿菌占絕大多數(80%)本病的誘發因素為患者常有嚴重的原發疾病如慢性肺部疾病、惡性腫瘤、燒傷、免疫功能低下和老年住院患者,通常發生於住院1周后;患者在套用激素免疫抑制劑和廣譜抗生素等,此可改變機體免疫功能及體內正常菌叢而導致菌群失調;臨床上各種導管的套用氣管插管、人工裝置和大手術等,常為感染的途徑;感染場所常為ICU、燒傷病房等。本菌屬引起的機會性感染包括皮膚傷口感染、泌尿生殖道感染肺炎、肺膿腫,還可引起敗血症、心內膜炎、腦膜炎、腦膿腫等,占醫院內感染的1%~3%。偶爾也可引起院外獲得性感染。臨床表現
不動桿菌感染臨床表現主要根據感染部位不同和病情輕重不一而症狀差異很大。
1.呼吸道感染 較為常見,多發生在有嚴重基礎疾病的患者如原有肺部疾患,長期臥床不起,接受大量廣譜抗菌藥物、氣管切開、氣管插管、人工輔助呼吸等。我國ICU患者呼吸道標本分離菌中,鮑曼不動桿菌排名第三(11%)表現有發熱,多為輕度或中度不規則發熱,咳嗽胸痛氣急,嚴重者可有發紺等表現。肺部可有中細濕囉音。胸部X線檢查常表現為支氣管肺炎,亦可為大葉性或片狀浸潤陰影,偶有膿腫或滲出性胸膜炎。可並發敗血症及腦膜炎。痰培養和氣管抽吸物培養有大量細菌生長。菌血症少見,如不及時治療,則病死率較高(40%~64%)。
2.敗血症 不動桿菌敗血症主要發生於醫院內感染。在敗血症2576株病原菌中,醫院內感染的不動桿菌在革蘭陰性桿菌中僅次於大腸桿菌、假單胞菌屬,與肺炎桿菌分離率幾乎相等,約占8%。而在醫院外感染九種革蘭陰性桿菌敗血症中,不動桿菌的發生率最少。不動桿菌敗血症多發生在使用留置的動、靜脈導管、導尿管或外科手術的患者,或患有嚴重基礎疾病、長期套用腎上腺皮質激素或細胞毒藥物等常與呼吸道感染合併發生。患者有發熱毒血症症狀、皮膚瘀點、肝脾腫大等,嚴重者可發生休克本病的病死率頗高(17%~46%),其中重要的原因是與該菌耐藥和多種細菌合併感染有關。鮑曼不動桿感染的病情通常較重,病死率也較高。
3.傷口皮膚感染 創口感染占該菌感染總數的17.5%發病率依次為外傷性感染、手術後感染燒傷後創面感染。創口感染也可由本菌和其他細菌構成混合感染。如腸桿菌屬、銅綠假單胞菌、腸球菌屬、葡萄球菌屬或化膿性鏈球菌造成混合感染。靜脈導管污染本菌可引起嚴重的皮膚蜂窩織炎。嚴重的創口感染常合併敗血症。
4.泌尿生殖道感染 該菌在泌尿生殖系統的檢出率較高,僅次於呼吸系統。國內有學者報導,該菌屬引起的尿道感染占28.6%。原發病有前列腺肥大尿道結石尿道狹窄,誘因多為留置導尿管、膀胱造瘺等。臨床表現為尿道炎、腎盂腎炎、陰道炎等,大多以該菌屬單獨感染為主,部分可混合其他細菌感染,尚有部分為無症狀帶菌者。
5.腦膜炎 大多發生於顱腦手術後也可為原發性感染,尤其在小兒中。誘發因素有顱腦外科手術、顱咽管瘤穿刺抽吸、腰椎穿刺等。臨床表現有發熱、頭痛、嘔吐、頸強直凱爾尼格征陽性等化膿性腦膜炎改變。嬰幼兒則有凝視、尖叫、驚厥、眼球震顫、前囟飽滿緊張、骨縫增寬和四肢肌張力增高。皮膚亦可出現瘀點、瘀斑臨床上易誤診為流行性腦脊髓膜炎,應加以注意。同時還可並發腦室炎腦膿腫、腦積水等。腦脊液檢查外觀混濁,細胞總數及中性粒細胞增高蛋白質增高,糖含量降低。肺脊液塗片可見革蘭陰性桿菌,可成雙排列。
6.其他 本菌尚可引起其他部位的感染,且形成化膿性炎症,如化膿性關節炎骨髓炎、腹膜炎腹腔膿腫、眼部感染和口腔膿腫等。
併發症:
可並發腦室炎、腦膿腫、腦積水、化膿性關節炎、骨髓炎、腹膜炎、腹腔膿腫、眼部感染和口腔膿腫。
診斷
本病臨床表現並無特徵性。醫院內感染、發生於有嚴重原發疾病患者的感染均要考慮本菌感染。機體抵抗力下降、免疫功能低下、老年和早產兒、氣管切開插管、久置動脈靜脈導管、導尿管、廣譜抗生素套用及監護室環境等均為重要易感因素。不動桿菌感染診斷有賴於細菌培養本菌與莫拉菌和奈瑟菌在形態上很相似,但也有一定區別。一般奈瑟菌為腎形,相對排列;莫拉菌則為短桿菌,成雙排列,兩端相連。不動桿菌的形態可因使用培養基不同而異。如用18~24h培養的瓊脂平板作塗片,則常為1.0μm×0.7μm的雙球菌;而用肉湯培養物塗片則呈典型的2.0μm×1.2μm的桿菌。根據生化反應不同可以鑑別。但是在判定結果時,應考慮到本菌特點,即不動桿菌分布廣泛營養條件要求低易於生長繁殖等特點致容易出現標本污染而發生假陽性,故應在嚴格消毒後採集標本。一般認為培養陽性2次以上方有診斷價值,如僅培養1次陽性,應結合臨床考慮,有無上述易感因素,藥物敏感試驗結果是否與臨床療效一致等情況進行綜合判斷。此外,尚需注意尿、痰或咽部培養陽性並不一定是致病菌須多次陽性或純培養方可判斷為致病菌。例如尿培養陽性者細菌計數應>10萬/ml;痰培養陽性者,每個乾板的不動桿菌菌落數應在30個以上。
鑑別診斷:
不動桿菌感染診斷有賴於細菌培養本菌與莫拉菌和奈瑟菌在形態上很相似但也有一定區別。一般奈瑟菌為腎形,相對排列;莫拉菌則為短桿菌,成雙排列兩端相連。
檢查
實驗室檢查:
白細胞總數明顯增高中性粒細胞達80%以上。
其它輔助檢查:
肺部X線檢查可表現為多葉性氣管支氣管肺炎,偶有膿腫形成及滲出性胸膜炎。腦脊液檢查外觀混濁,細胞總數及中性粒細胞增高。
治療
本病的治療原則是立即去除易感因素如儘可能拔去久置的導管,必要時重新放置,同時及時處理引起免疫力降低的各種因素,並給予支持治療選用有效的抗生素以控制感染。應強調使用抗菌藥物前,根據不同的感染部位,採用相應的標本作細菌培養及藥物敏感性測定,以便選用恰當抗菌藥物近年來本菌對臨床常用抗生素普遍耐藥,且出現多重耐藥菌株。對青黴素、氨苄西林苯唑西林氯黴素、紅黴素、頭孢孟多等均耐藥。不斷發生的不動桿菌醫院內ICU暴發流行和廣譜抗生素的大量使用,使該菌對過去敏感的抗生素亦呈進展性耐藥:包括米諾環素、多黏菌素。第三代頭孢菌素的敏感率亦下降到50~60%。由於近年來常以氨基糖苷類藥物和氟喹諾酮類藥物作為第一線藥物,因而該菌對氨基糖苷類和氟喹諾酮類藥物的耐藥性明顯增加,如環丙沙星的耐藥率已上升到30%~60%。近來曾發生耐慶大黴素、阿米卡星的菌株流行,但對妥布黴素仍敏感。不動桿菌耐藥的機制包括產生滅活酶(β內醯胺酶、氨基糖苷類鈍化酶)細菌外膜乳蛋白改變和PBPs改變等。對於多重耐藥的流行株,目前僅亞胺培南、舒他西林(氨苄西林-舒巴坦)和頭孢哌酮/舒巴坦的治療反應較好。亞胺培南(imipenem)抗菌譜極廣,抗菌活性非常強,對本菌有良好作用,其耐藥率通常小於5%舒他西林(氨苄西林-舒巴坦)對不動桿菌抗菌活性,可能與β內醯胺酶抑制劑可以恢復氨苄西林的絕大多數抗菌活性有關。近年來全球範圍內鮑曼不動桿菌對亞胺培南的耐藥率已出現快速增長,並存在明顯的地區差異。2000年美國15家醫學中心的資料顯示,不動桿菌對碳青黴烯類耐藥率為19%~22%我國台灣最近報導2000年ICU中的鮑曼不動桿菌對亞胺培南耐藥率為22%。1994~1995年北京、上海等六家醫院聯合監測ICU分離的118株不動桿菌對亞胺培南的耐藥率為14%。上海地區11家醫院2000年4月至2001年3月的統計,不動桿菌屬對亞胺培南和美羅培南敏感率分別為96.8%和94.4%。有資料顯示:限制碳青黴烯類抗生素的使用,可使鮑曼不動桿菌的感染率明顯下降。如1992年西班牙巴塞隆納一家醫院出現一起多重耐藥鮑曼不動桿菌引起的醫院感染暴發流行,導致大量使用亞胺培南,1997年該院ICU出現耐亞胺培南鮑曼不動桿菌並迅速擴散。於是關閉所有ICU並徹底消毒,嚴格執行預防交叉傳播的措施,結果鮑曼不動桿菌的感染率明顯減少。限制併合理使用碳青黴烯類抗菌藥,加強細菌耐藥性的監測是防止和延緩鮑曼不動桿菌耐藥的重要措施。由於耐亞胺培南鮑曼不動桿菌可同時對多種抗菌藥包括氨基糖苷類和氟喹諾酮類耐藥,目前用於治療耐亞胺培南的鮑曼不動桿菌感染可選藥物極為有限,國外報導舒他西林(氨苄西林-舒巴坦)、頭孢哌酮/舒巴坦、多黏菌素E和多黏菌素B、新生黴素等對耐亞胺培南鮑曼不動桿菌感染有效對於腦膜炎患者,由於氨基糖苷類不易透過血-腦屏障,全身用藥藥物濃度甚低,不能達到殺菌效果,故須加用鞘內注射。妥布黴素、阿米卡星或慶大黴素,鞘內注射成人均為5~10mg/次,兒童為成人的1/2量。有腦室炎者,尚需作側腦室注射每天或隔天注射1次。或採用第三代頭孢菌素聯合氨基糖苷類治療呼吸道不動桿菌感染者使用舒他西林(氨苄西林-舒巴坦)聯合阿米卡星或亞胺培南治療是一個較好的選擇。但最終選擇還應根據臨床藥敏檢測結果。
預後預防
預後:
預後與感染輕重和感染部位有明顯關係:①有難治性基礎疾病或引起免疫功能下降的誘因未得以糾正;②耐藥菌株感染及未及時套用有效的抗生素;③是否發生敗血症、心內膜炎、腦膜炎,有昏迷、抽搐、譫妄等者一般提示預後較差。
預防:
1.積極治療原發疾病儘早去除誘因,如各種導管及時停用激素、廣譜抗生素等
2.醫院工作人員一定要認真洗手接觸患者後均應洗手並用苯扎溴銨等消毒劑泡手。
3.原來感染的人一旦離開對病室進行認真清洗消毒,對患者用過的導管、氣管插管等應專門清洗、消毒。
4.限制廣譜抗菌藥物長期套用,儘可能地選用對人體正常菌群影響不大的藥物治療其他細菌性感染
5.增強患者體質,提高免疫功能,是防止醫院內感染的主要措施。